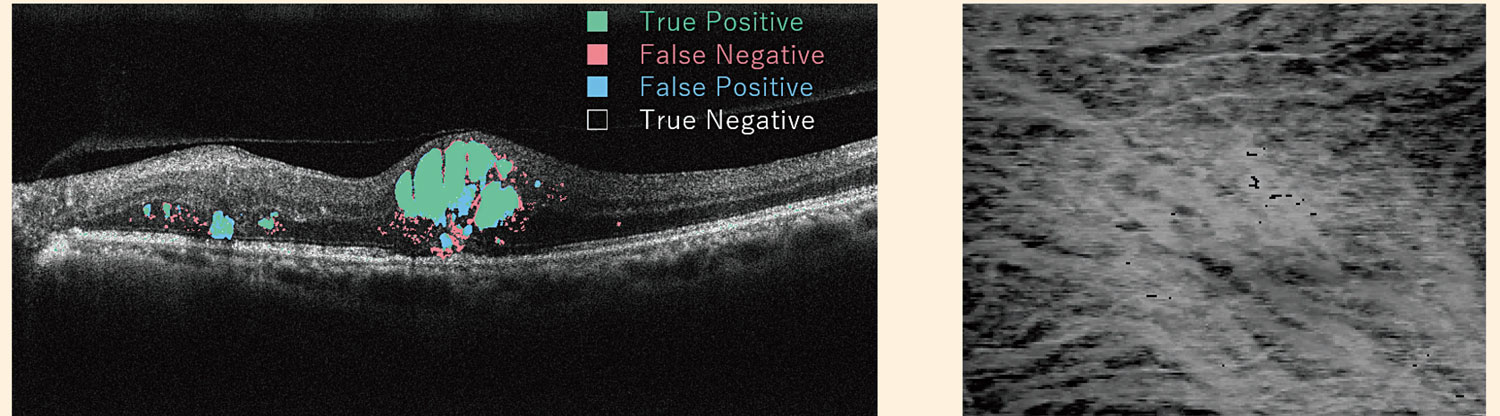

眼循環代謝学 Ocular Circulation and Metabolism
グループチーフ:齋藤 理幸
眼循環代謝学研究グループについてご紹介させて頂きます。本研究グループは、眼循環代謝学講座を引き継ぎ、今年度から正式に研究グループとして立ち上げました。研究手法はイメージングで、近年急速に発達しているAIを用いて画像解析を行い各疾患の病態に迫る仕事をしています。現在進行中の主なプロジェクトに以下のものがあります。
- 眼底写真を用いた網膜血管解析…福津先生が主に取り組んでおり眼底写真上の網膜血管をセマンティックセグメンテーションにより抽出し解析します。これまでに年齢や血圧、動脈硬化(PWVやCVI)、男女差や糖尿病における血管変化を同定し論文作成に取り組んでいます。
- 網膜浮腫の解析…大学院生の三田村先生が行ってくれています。網膜浮腫のインデックスとして従来の網膜厚がありますが、網膜液(MF)を詳細に同定することによってこれまでよりもインパクトのある解析が可能です。現在、嚢胞切開術後のMFの変化や糖尿病の病期によって変化するMF内の輝度や分散についての解析を終了し論文を投稿中です。
- パキコロイドの解析、本課題は私が従来から取り組んでいるものでもあり、血流・脈絡膜曲率・AI index・choroidal fluidなどパキコロイドの病態を的確に表すインデックスを作成し様々な疾患におけるパキコロイドとの関連を明らかにすることを目的に行っています。
AIは臨床研究の基本であるインデックス作成と非常に相性の良いツールであり、既存の研究を全て塗り替えられるほどのインパクトを持っています。今後も皆様の御支援を賜りたくよろしくお願い申し上げます。ご期待ください。
We would like to introduce the Ocular Circulation and Metabolism Research Group. This research group has taken over from the Department of Ocular Circulation and Metabolism and was officially established as a research group this year. We are using artificial intelligence (AI), which has developed rapidly in recent years, to analyse medical images and work to clarify the pathology of various diseases. The main projects currently underway are
- Retinal vessel analysis using fundus photographs: We used a semantic segmentation technique to extract and analyse retinal vessels on fundus photographs. Dr Fukutsu is the main investigator and has so far identified vascular changes in relation to age, blood pressure, atherosclerosis (PWV and CVI), gender differences and diabetes, and is working on papers.
- Analysis of macular edema: This is being carried out by PhD student Dr Mitamura. Although the conventional method of analyzing macular edema is to measure the retinal thickness, the detailed identification of the retinal fluid (MF) allows a more powerful analysis than before. At present, we have completed the analysis of the changes in MF after cystotomy and the changes in brightness and valiance of MF according to the stage of diabetes retinopathy and are currently submitting papers.
- Analysis of the pachylodoid: This is a topic I have been working on for some time and the aim is to create indices that accurately represent the pathology of the pachylodoid per se, such as blood flow, choroidal curvature, AI index and choroidal fluid, and to clarify the relationship between the pachylodoid and various pachychoroidal diseases.
AI is a tool that is very compatible with the creation of indices that are the basis of clinical research, and it has the potential to have an impact that will rewrite much of existing research. We would like to ask for your continued support in the future. Please look forward to it.

眼底写真から網膜血管を分離同定
左: 網膜内液のsemantic segmentationによる解析
右:3D-OCTデータから再構成したchoroidal fluid画像



